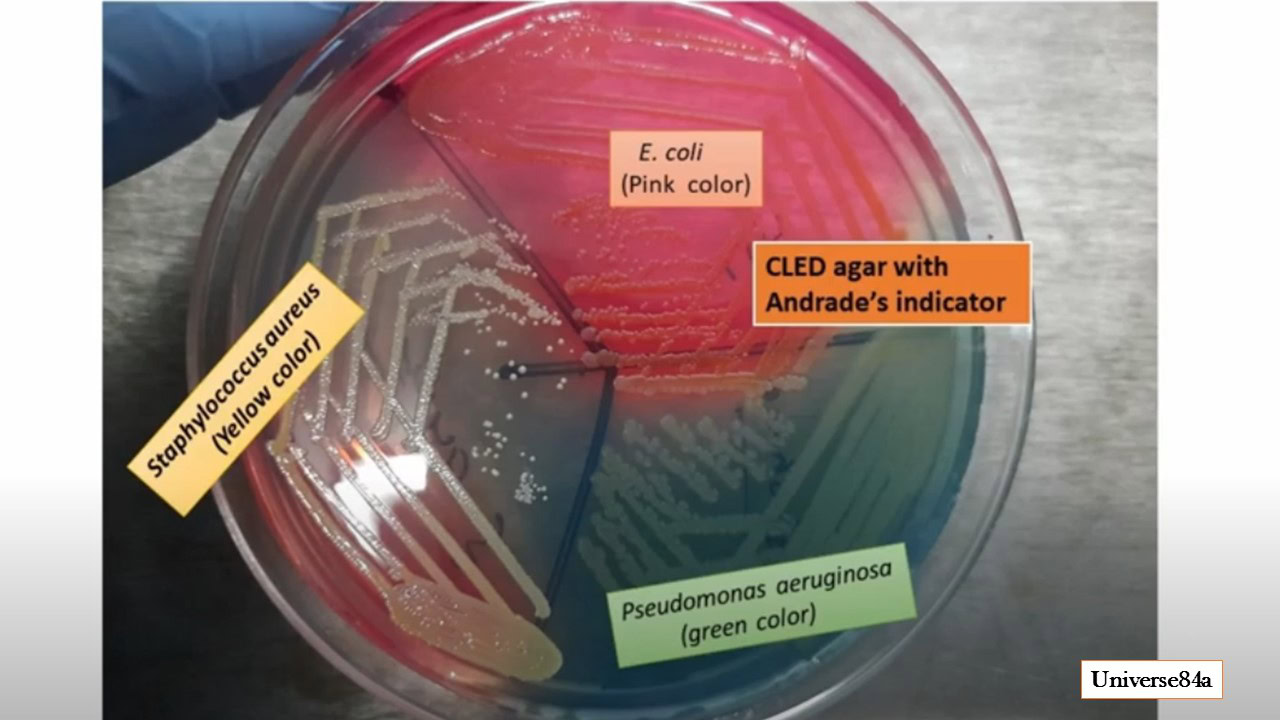
E. coli berwarna pink, stir lays di agar CLED dengan indikator Anderson, menunjukkan keberhasilan pertumbuhan dan identifikasi bakteria di media kultur.

Tidak ada produk di keranjang.
BAHAN HABIS PAKAI, BIOSAINS, LABORATORIUM UMUM
CARA MENGGUNAKAN CLED MEDIUM
Artikel ini akan membahas tentang berbagai kegunaan dan cara menggunakan CLED Medium. Simak artikel ini sampai selesai.
Dalam dunia mikrobiologi klinis, media kultur memegang peran penting untuk mengidentifikasi penyebab infeksi secara akurat. Salah satu media yang sering penggunaannya adalah CLED Medium. Media ini sangat efektif dalam mendeteksi bakteri penyebab infeksi saluran kemih karena memiliki sifat selektif sekaligus diferensial. Dengan formulasi khusus, CLED Medium membantu laboratorium menghasilkan data mikrobiologi yang lebih jelas dan andal.
APA ITU CLED MEDIUM?
CLED Medium (Cystine Lactose Electrolyte Deficient Medium) adalah media kultur untuk isolasi serta diferensiasi mikroorganisme penyebab infeksi saluran kemih. Media ini mengandung laktosa sebagai sumber karbohidrat, indikator pH berupa bromthymol blue, dan tidak memiliki elektrolit yang tinggi sehingga menghambat fenomena swarming bakteri Proteus. Hasilnya, koloni bakteri dapat tumbuh dengan jelas, memudahkan proses identifikasi.
APA SAJA KEGUNAANNYA?
CLED Medium memiliki banyak kegunaan penting, antara lain:
Isolasi bakteri penyebab infeksi saluran kemih
Media ini dapat menumbuhkan bakteri patogen dari sampel urin.
Diferensiasi bakteri fermentatif dan non-fermentatif
Bakteri yang mampu memfermentasi laktosa menghasilkan koloni berwarna kuning, sedangkan bakteri non-fermentatif menghasilkan koloni berwarna biru.
Menghambat swarming Proteus
Kandungan elektrolit yang rendah mencegah dominasi Proteus, sehingga memudahkan pengamatan koloni lain.
Mendukung analisis klinis
Media ini berguna pada laboratorium klinik sebagai bagian dari pengujian mikrobiologi rutin.
Baca juga: Kalibrasi Vectra 3 Automated Quantitative Pathology Imaging System
BAGAIMANA CARA MENGGUNAKANNYA?
Berikut adalah langkah-langkah penggunaan medium ini:
Persiapan media
- Timbang bubuk CLED Medium sesuai instruksi produsen.
- Larutkan dalam air suling dengan pemanasan hingga homogen.
- Sterilisasi menggunakan autoklaf pada suhu 121°C selama 15 menit.
Penuangan media
- Tuangkan media steril ke dalam cawan petri dalam kondisi aseptik.
- Biarkan media memadat pada suhu ruang.
Inokulasi sampel
- Gunakan metode loop atau inokulasi langsung dengan sampel urin.
- Sebarkan sampel secara merata di permukaan media untuk memperoleh koloni terpisah.
Inkubasi
- Inkubasi cawan pada suhu 35–37°C selama 18–24 jam.
- Amati pertumbuhan koloni serta perubahan warna yang terjadi.
Interpretasi hasil
- Koloni fermentasi laktosa → kuning.
- Koloni non-fermentasi → biru.
- Pengamatan pertumbuhan bakteri dengan jelas karena swarming Proteus tidak terjadi.
CLED Medium adalah media kultur yang efektif untuk isolasi serta diferensiasi bakteri penyebab infeksi saluran kemih. Dengan kemampuan mencegah swarming *Proteus* dan memisahkan koloni berdasarkan fermentasi laktosa, media ini menjadi pilihan utama laboratorium klinis. Pemakaian yang tepat sesuai prosedur akan memberikan hasil uji yang akurat dan bermanfaat dalam diagnosis medis.
Itulah pembahasan tentang kegunaan dan cara menggunakan CLED Medium. Semoga artikel ini dapat bermanfaat.
Sumber:
CLED Agar- Composition, Principle, Preparation, Results, Uses (microbenotes.com)
CLED Medium: Introduction, Uses,Composition, Preparation, Colony Char (universe84a.com)